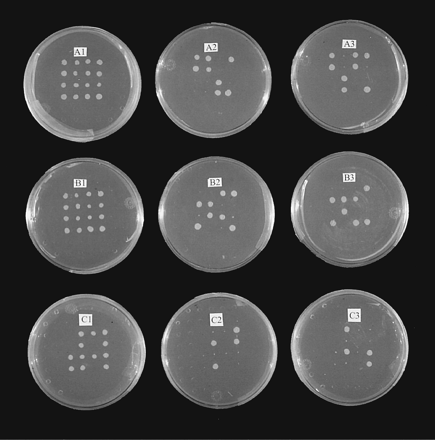
Figure 5.

Tetrad dissection of LAG1 transformants. Tetrads are arranged vertically. (A) LAG1Hs transformants. (A1) Dissected spores from tetrads grown on a ura− plate. (A2) Colonies replicated from A1 grown on a ura− and leu−plate. (A3) colonies replicated from A1 grown on a ura− and trp− plate. Carbon sources were 2% galactose and 1% raffinose. (B) LAG1Ce-1 transformants. B1,B2, and B3 plates were the same as A1,A2, and A3, respectively. (C) HumanTRAM transformants. C1, C2, and C3plates were the same as A1, A2, and A3, respectively.











